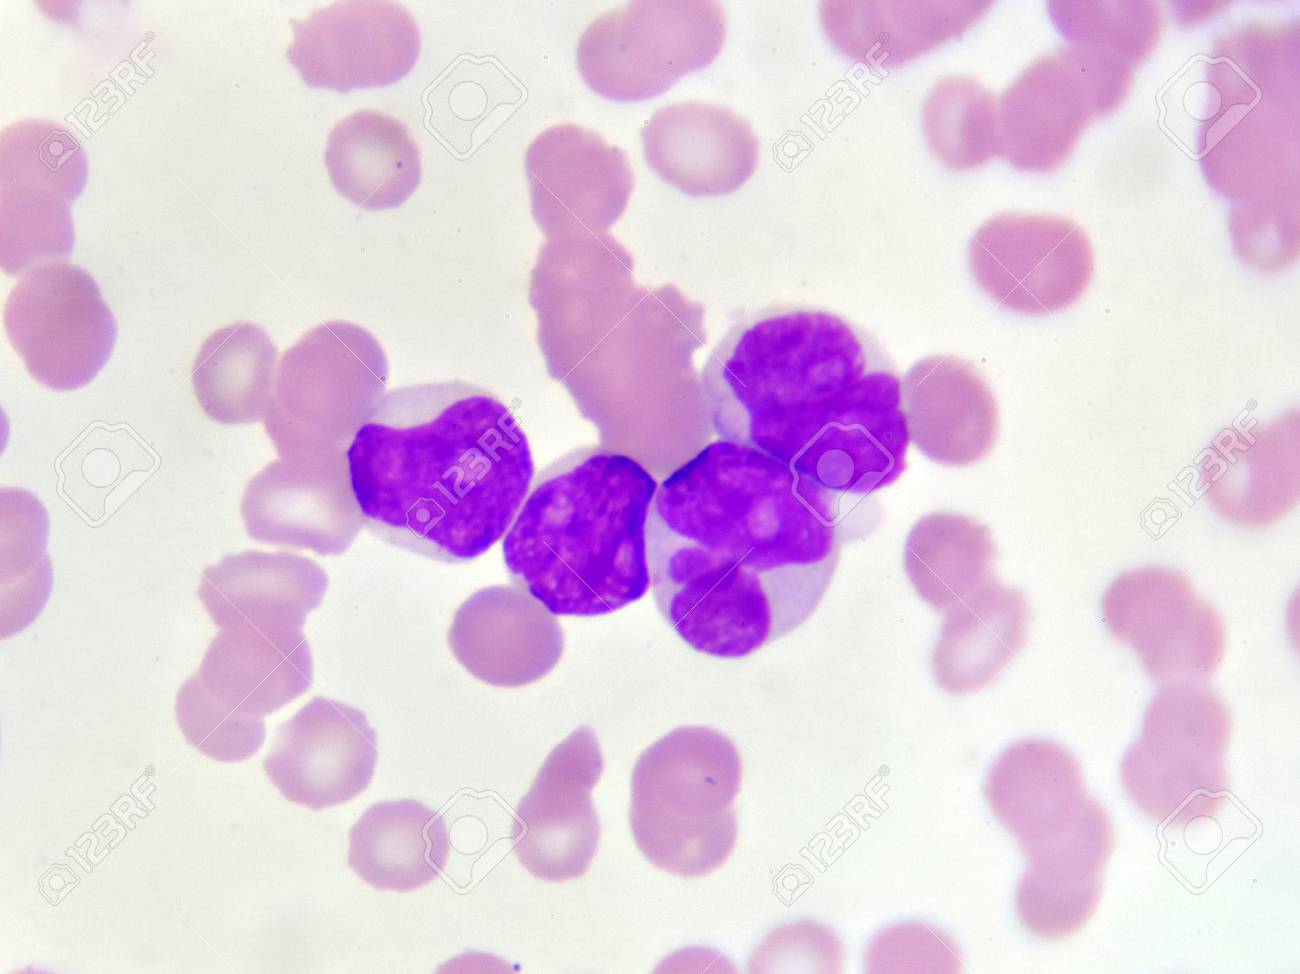
急性骨髄性白血病の血液像 の写真素材 画像素材 Image 87172720

血液 像 と は

急性骨髄性白血病 Aml の血液像 の写真素材 画像素材 Image 85333023

ネットで形態 血液形態自習塾 第2部 末梢血 骨髄像の見方 考え方 ベックマン コールター
血液 輸血検査室 当科の特色 臨床研究検査科 医療支援部門 診療のご案内 Ja広島総合病院


臨床検査センター 血液検査室 広島大学

1 11373 0100 バッファータブレット Ph6 4 血液像用リン酸緩衝液調製用 1錠 1l 100錠入り 111373 100tabs Merck メルクミリポア 1個 通販モノタロウ 38575934

Medical Technology 43巻3号 末梢血液像を読む 自動血球計数装置の基礎とデータの有効活用 4 セルダインサファイア アボット

検査内容変更のお知らせ 血液像 白血球分類 日本医学臨床検査研究所
血液 凝固線溶検査 南奈良総合医療センター 南和広域医療企業団

鹿児島市医報

血液検査 臨床検査部 順天堂医院
急性骨髄性白血病の血液像 の写真素材 画像素材 Image 87172720
Belum ada Komentar untuk "血液 像 と は"
Posting Komentar